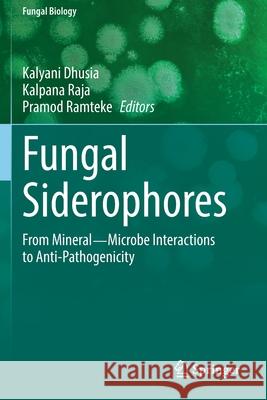
Fungal Siderophores: From Mineral―microbe Interactions to Anti-Pathogenicity Dhusia, Kalyani 9783030530792 Springer

» książki » Science - Life Sciences - Mycology
 |
Trends in the Systematics of Bacteria and Fungi
ISBN: 9781789244984 / Angielski / Twarda / 352 str. Termin realizacji zamówienia: ok. 5-8 dni roboczych. |
cena:
680,83 zł |
 |
Grow Your Own Mushrooms: How to Choose, Grow and Cook Them
ISBN: 9780857845252 / Angielski / Miękka / 96 str. Termin realizacji zamówienia: ok. 5-8 dni roboczych. |
cena:
76,97 zł |
 |
Fungi in Sustainable Food Production
ISBN: 9783030644055 / Angielski / Twarda / 234 str. Termin realizacji zamówienia: ok. 5-8 dni roboczych. |
cena:
403,47 zł |
 |
The Mycocultural Revolution: Transforming Our World with Mushrooms, Lichens, and Other Fungi
ISBN: 9781621065142 / Angielski / Twarda / 128 str. Termin realizacji zamówienia: ok. 5-8 dni roboczych. |
cena:
68,99 zł |
 |
Magnaporthe Oryzae: Methods and Protocols
ISBN: 9781071616123 / Angielski / Twarda / 234 str. Termin realizacji zamówienia: ok. 5-8 dni roboczych. |
cena:
887,69 zł |
 |
Advances in Macrofungi
ISBN: 9781032042770 / Angielski / Twarda / 314 str. Termin realizacji zamówienia: ok. 5-8 dni roboczych. |
cena:
780,44 zł |
 |
Covid-19: Biomedical Perspectives: Volume 50
ISBN: 9780323850612 / Angielski / Twarda Termin realizacji zamówienia: ok. 5-8 dni roboczych. |
cena:
678,01 zł |
 |
Mushrooms: An Illustrated Field Guide
ISBN: 9781951511319 / Angielski / Miękka / 128 str. Termin realizacji zamówienia: ok. 5-8 dni roboczych. |
cena:
57,46 zł |
 |
Extremophilic Fungi: Ecology, Physiology and Applications
ISBN: 9789811649066 / Angielski / Twarda Termin realizacji zamówienia: ok. 5-8 dni roboczych. |
cena:
1008,75 zł |
 |
Mushrooms of Gujarat
ISBN: 9789811649981 / Angielski / Twarda / 134 str. Termin realizacji zamówienia: ok. 5-8 dni roboczych. |
cena:
403,47 zł |
 |
Art of Nature: Fungi Boxed Card Set (Set of 20 Cards): (Gifts for Mushroom Enthusiasts and Nature Lovers)
ISBN: 9781647224042 / Angielski / Other Termin realizacji zamówienia: ok. 5-8 dni roboczych. |
cena:
72,98 zł |
 |
Jacob Bolton: Geschichte Der Merckwürdigsten Pilze. Teil 3
ISBN: 9783112411278 / Niemiecki / Twarda / 94 str. Termin realizacji zamówienia: ok. 5-8 dni roboczych. |
cena:
468,31 zł |
 |
The Lives of Fungi: A Natural History of Our Planet's Decomposers
ISBN: 9780691229843 / Angielski / Twarda / 288 str. Termin realizacji zamówienia: ok. 5-8 dni roboczych. |
cena:
115,10 zł |
 |
Field Guide to Wood Decay Fungi on Florida Trees
ISBN: 9781456638092 / Angielski / Miękka / 138 str. Termin realizacji zamówienia: ok. 5-8 dni roboczych. |
cena:
115,10 zł |
 |
Trichoderma reesei: Methods and Protocols
ISBN: 9781071610503 / Angielski / Miękka Termin realizacji zamówienia: ok. 5-8 dni roboczych. This detailed book collects standard techniques and cutting-edge methods that are frequently used by the research community studying the fungus Trichoderma reesei. Beginning with overviews of its evolution, its use in the production of industrially-relevant enzymes, and synthetic biology applications, the volume continues with methods covering topics from transformation techniques and gene editing to downstream-analytical applications and -omics analyses and the corresponding bioinformatics approaches. Written for the highly successful Methods in Molecular Biology series,...
This detailed book collects standard techniques and cutting-edge methods that are frequently used by the research community studying the fungus Tri...
|
cena:
443,82 zł |
 |
Methods in Recombinant Protein Production: Volume 51
ISBN: 9780128211779 / Angielski / Twarda Termin realizacji zamówienia: ok. 5-8 dni roboczych. |
cena:
678,01 zł |
 |
Host-Fungal Interactions
ISBN: 9781071611845 / Angielski / Miękka Termin realizacji zamówienia: ok. 5-8 dni roboczych. This volume provides readers with essential protocols for dissecting the host-fungus interaction, and engages researchers in study of mammalian disease. Written in the highly successful Methods in Molecular Biology series format, chapters include introductions to their respective topics, lists of the necessary materials and reagents, step-by-step, readily reproducible laboratory protocols, and tips on troubleshooting and avoiding known pitfalls. Authoritative and cutting-edge, Host-Fungal Interactions: Methods and Protocols aims to ensure successful results... This volume provides readers with essential protocols for dissecting the host-fungus interaction, and engages researchers in study of mammalian dis... |
cena:
484,18 zł |
 |
Internationales Symposium Systemfungizide / Systemic fungicides
ISBN: 9783112580974 / Niemiecki / Twarda / 356 str. Termin realizacji zamówienia: ok. 5-8 dni roboczych. |
cena:
468,31 zł |
|
Fungal Siderophores: From Mineral―microbe Interactions to Anti-Pathogenicity
ISBN: 9783030530792 / Angielski / Miękka / 228 str. Termin realizacji zamówienia: ok. 5-8 dni roboczych. |
cena:
685,93 zł |
 |
Mycology in the Tropics: Updates on Philippine Fungi
ISBN: 9780323994897 / Angielski / Miękka Termin realizacji zamówienia: ok. 5-8 dni roboczych. |
cena:
560,94 zł |













